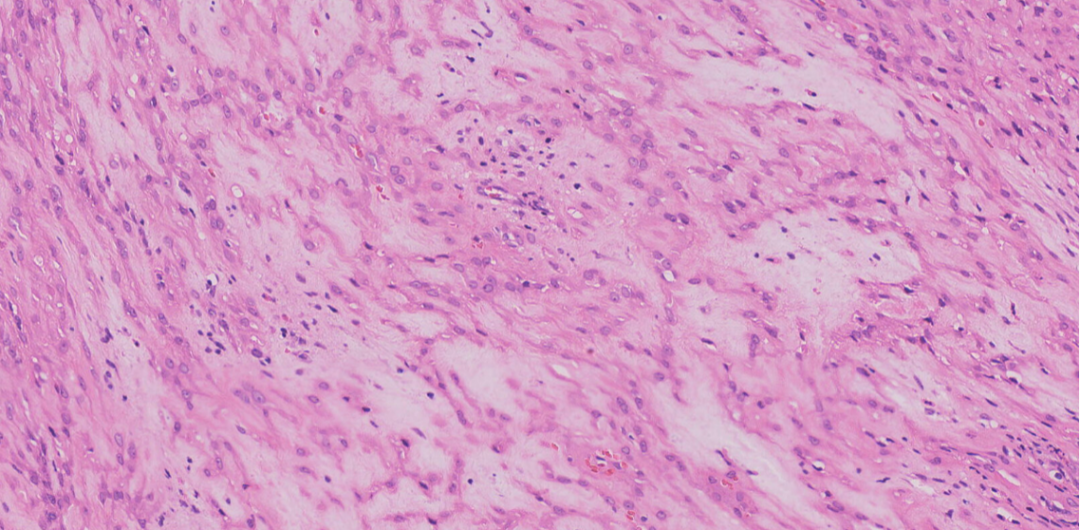
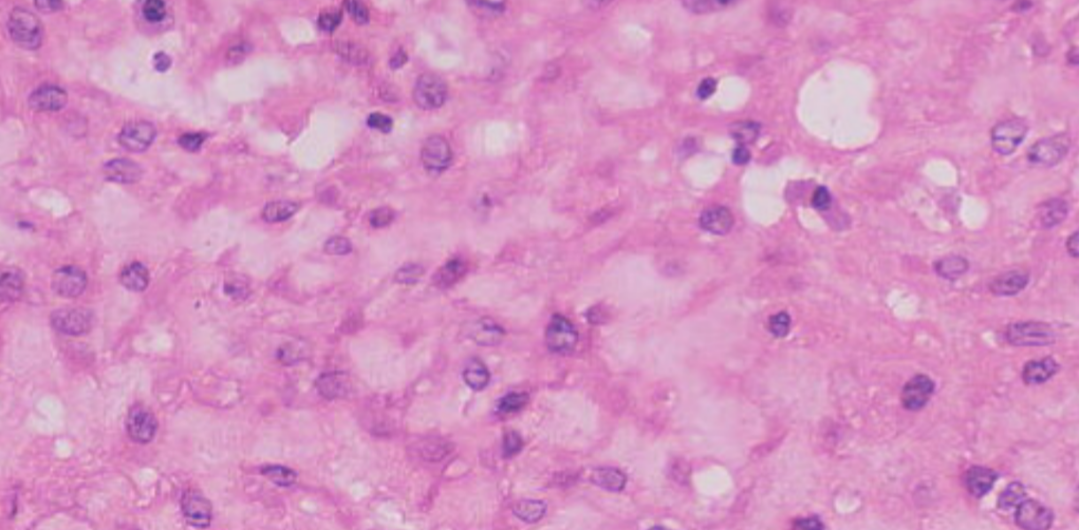
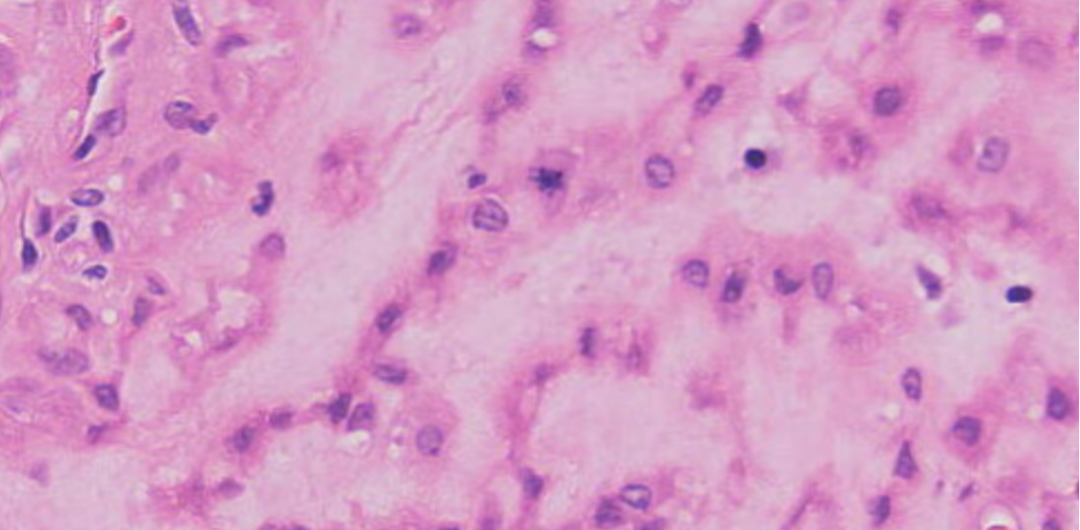

讲座|阴道壁肿物病例分享
阴道前壁包块)灰红结节状组织一块,大小2.8*2.5*1.0cm,组织切面灰红灰白质中,部分半透明,界限清。

肿瘤位于粘膜下,呈多结节状生长,界限尚清。


中倍镜下肿瘤结构呈丛状,条索状生长,间质黏液变性

肿瘤呈丛状,条索状生长,间质黏液变性
细胞温和,圆形、多边形,胞浆丰富,嗜酸性,可见核仁
偶见核分裂







免疫组化结果:CK7(-)、CK5/6(-)、P63(-)、PAX-8(-)、Ki-67(+,约2%+)、INI-1(+,未突变)、SMA(+)、Des(+)、CD34(-)、S-100(-)、ER(+)、CK(-)、ALK(-)
(阴道前壁包块):上皮样平滑肌瘤伴黏液变性,富于细胞性,请结合临床并密切随诊。
讨论:发生于女性生殖道、具有上皮样细胞形态的良性平滑肌肿瘤,是女性生殖道间叶源性肿瘤中的相对罕见类型。
在确认平滑肌免疫表型SMA/Desmin/h-Caldesmon+的基础上,识别其上皮样形态。其部位特异性决定了鉴别诊断谱与子宫来源者截然不同,需重点排除阴道更常见且形态可重叠的肿瘤。
平滑肌瘤,多见于子宫,少见阴道与外阴部位;
边界:相对清楚,但无包膜。质地与色泽:灰白至黄褐色,质软或韧,缺乏典型平滑肌瘤的编织状纹理。
继发改变:常见玻璃样变性,及黏液样变区。
鉴别诊断:1、肌上皮瘤
形态学常呈多结节状或分叶状,伴数量不等的黏液样、软骨样或玻璃样变的间质成分,瘤细胞可为梭形、卵圆形或上皮样,细胞核为均一的卵圆形或圆形,胞质嗜酸性至透明表现。
一般同时表达上皮标记和S-100,但很多病例在免疫组化方面会有变化,大部分病例(93%-100%)都会表达广谱CK,大约50%病例存在EWSR1基因重排。
2.肌上皮瘤样肿瘤(伴INI-1/SMARCB1缺失的肿瘤)
大体呈结节状或分叶状,部分可见黏液区域,肿瘤由黏液区和非黏液区组成,细胞呈上皮样或梭形细胞。
NI-1/SMARCB1(缺失)
3.侵袭性血管黏液瘤
细胞稀疏(星形/梭形),弥漫分布于显著水肿或黏液样间质中,可见厚壁玻璃样变血管。
ER/PR弥漫强阳性,Desmin可阳性,但h-Caldesmon通常阴性或弱阳,SMA不定。
4.上皮样平滑肌肉瘤(恶性鉴别)
明确的肿瘤性坏死、显著的核异型性、活跃的核分裂象(>5/10 HPF);具备其中两项应高度怀疑。
浸润性边缘,Ki-67指数显著增高(常>10%)。
5.血管周上皮样细胞肿瘤
镜下:上皮样、透亮细胞,形态高度重叠。
免疫组化:确诊依据—HMB45、Melan-A等黑色素标志阳性。
6.浅表性血管黏液瘤
多灶性,位于真皮/皮下,边界不清。
间质为疏松黏液样,细胞成分少,血管丰富。
缺乏平滑肌免疫表型。
总结:上皮样平滑肌瘤是一种具有独特形态的良性平滑肌肿瘤,诊断依赖于特征性的上皮样形态、典型的肌源性免疫表型(SMA+/h-Caldesmon+/Desmin+),以及谨慎地排除一系列重要且相似的病变,准确的诊断对临床处理(局部切除 vs. 更广泛手术)至关重要。

